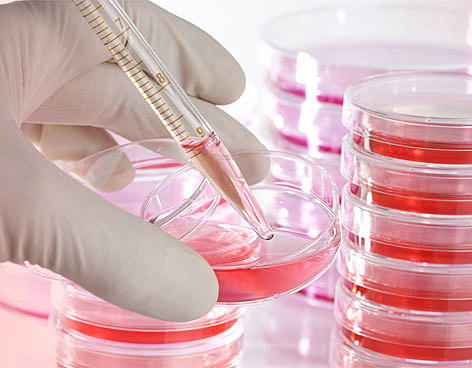
2004

-
Descubrimiento del fuego
-
Egipto, China e India experimentan con técnicas de alfarería.
-
Inicia el desarrollo de la fermentación.
-
China descubre el electromagnetismo
-
Aristóteles concibe los 4 elementos componentes de todo
-
Paracelso y el comienzo de la iatroquímica
-
Lucrecio explica el concepto de átomo
-
Fahrenheit fabrica el termómetro de alcohol y más tarde el de mercurio
-
Promulgación de la ley de la conservación de la materia
-
Método de nomenclatura de Lavoisier y Morveau
-
Dalton y las leyes de proporciones atómicas
-
Wöhler sintetiza aunque a partir de compuestos inorgánicos. División de la química orgánica e inorgánica.
-
Mendeleiev publica la "Tabla periódica de los elementos".
-
Inicia la era de la petroquímica.
-
Röntgen descubre los rayos x.
-
Rutherford y el concepto del núcleo atómico.
-
Marie Curie y su esposo aislan el radio.
-
Descubrimiento del protón y el neutrón.
-
Producción de insulina
-
Müller implementa el uso del DDT.
-
Luis Miramontes inventa la píldora anticonceptiva.
-
Se lanza la bomba de hidrógeno.
-
Inició la investigación de los CFC.
-
Robert Curl, Kroto y Smalley Rick Harold descubren una nueva clase de compuestos de carbono con una estructura de jaula.
-
Mario Molina recibe el premio Nobel de química por trabajos CFCS.
-
La ingeniería genética experimenta con células madre
-
Se descubre el material más delgado y resistente del mundo "grafeno".
-
Investigadores de CSIC descubrieron un nuevo polisacárido, un glucano de aplicación sanitaria, química y hasta alimentaria.
-
Se descubre gracias a investigadores de ENCODE qué el llamado "ADN basura" es mas importante de lo que se pensaba, siendo este, escencial para que los genes humanos funcionen, ya que regula su actividad.